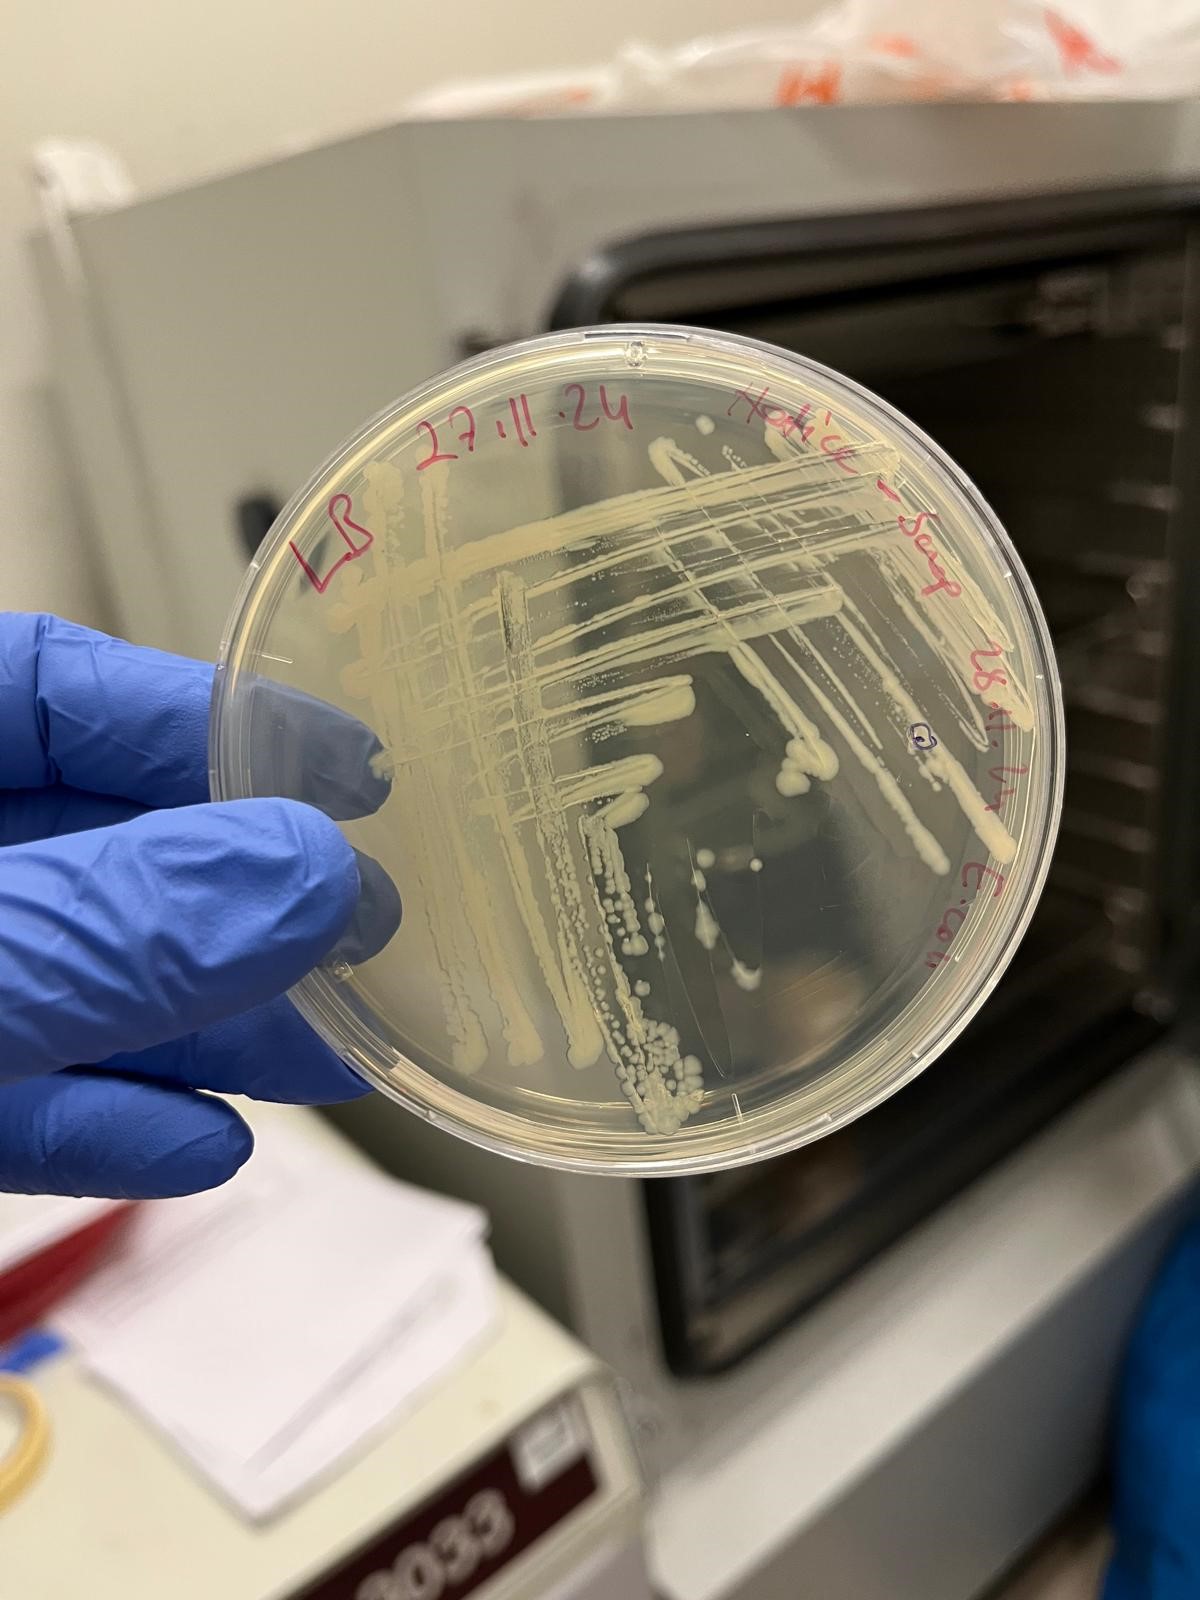

Bursa Uludağ Üniversitesi (BUÜ) Fen Edebiyat Fakültesi Moleküler Biyoloji ve Genetik Bölümü Öğretim Üyesi Prof. Dr. Aydın Türkeç liderliğindeki proje, TÜBİTAK 2025 yılı 1. Dönem ‘’1001 -Bilimsel ve Teknolojik Araştırma Projelerini Destekleme Programı’’ kapsamında desteklenmeye hak kazandı. Bu önemli proje, iklim değişikliği ve uzay çalışmaları gibi geleceğin en büyük sorunlarına çözüm sunma potansiyeli taşıyor.
Tardigratların sırrını çözmeye çalışacaklar
“Su ayısı” olarak da bilinen ve aşırı zorlu şartlara dayanıklılığıyla ünlü tardigratların sırrı, bilim insanları tarafından çözülmeye çalışılacak. “Türkiye’ye özgü tardigrat türlerinin abiyotik stres adaptasyon mekanizmalarında rol oynayan moleküler yolakların belirlenerek yeni proteinlerin tanımlanması ve bitki hücrelerindeki biyokoruyucu potansiyelinin araştırılması” başlıklı proje, Türkiye’deki tardigrat türlerinin kuraklık ve UV-C ışınları gibi stres faktörlerine karşı gösterdiği inanılmaz dayanıklılığın moleküler mekanizmalarını aydınlatmayı hedefliyor.

Geleceğe umut olacak
Proje hakkında bilgi veren Prof. Dr. Aydın Türkeç , “Sabancı Üniversitesi Nanoteknoloji Araştırma ve Uygulama Merkezi işbirliğiyle yürüteceğimiz bu proje, DSUP adını verdiğimiz koruyucu proteinleri ve bu proteinlere benzeyen genleri taşıyan bitkileri belirlemeye odaklanıyor. Elde edeceğimiz örneklerle, gelecekteki iklim değişikliklerine ve uzay yolculuklarına dayanıklı bitkiler geliştirmek için tardigratlardan elde edilen genetik kaynakların kullanılabilirliğini ortaya koyacağız. Bu durum, bitkilerin kuraklık ve diğer çevresel stresli şartlara karşı daha dirençli hale getirilmesi için yeni kapılar aralayacak” açıklamasında bulundu.

Prof. Dr. Aydın Türkeç’in yürütücülüğünü üstlendiği projenin ekibinde Ahmet Altındağ, Duygu Berdi, StuartLucas ve Nihal Öztolan Erol araştırmacı, Zehra Çobandede ise danışman olarak yer alıyor.

